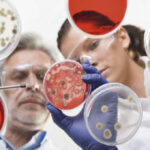

Las autoridades apuntan al turismo en las fiestas para reactivar economía.
Chordeleg, Oña y Sígsig celebran un aniversario más de cantonización. Las autoridades municipales apuntan al turismo con el propósito de reactivar la economía tras dos años de la pandemia de la COVID-19.
Los desfiles, shows artísticos, así como ferias y otras actividades masivas se retoman este año, considerando la disminución de las restricciones como resultado del bajo índice de contagios en la provincia del Azuay. Los tres cantones suman una inversión de 140 mil dólares para sus festividades.
Chordeleg cumple 30 años de cantonización. La municipalidad invierte cerca de 70 mil dólares en más de 30 eventos sociales, deportivos y culturales. Para su alcalde, Deifilio Arévalo, es la oportunidad para consolidar la reactivación económica en el cantón que inició en octubre del año pasado cuando las joyerías, zapaterías y otras actividades comerciales sintieron nuevamente la presencia de turistas de diferentes partes del Ecuador.
Asimismo, contar con el 90 % de personas vacunadas en el cantón es otro factor importante para potenciar el turismo y generar mayores ingresos económicos a sus habitantes.
De su parte, San Felipe de Oña celebra 31 años de emancipación política. El cabildo destina unos 30 mil dólares para los eventos que constan en la agenda que se presentó ayer en los patios de la Casa de la Provincia, en Cuenca, junto con las tres aspirantes a reina del cantón. El alcalde Iván Ullauri cree que los artesanos y emprendimientos gastronómicos se potenciaron a raíz de la pandemia. Por tal motivo, en la agenda festiva se cuenta con espacios para la venta de sus productos, entre otras actividades masivas.
“Todavía falta para una adecuada reactivación económica de Oña. Se necesita más atención de las instituciones de Gobierno, especialmente con técnicos para aprovechar mejor los emprendimientos que existen”, citó Ullauri.
Mientras que Sígsig conmemora 158 años de cantonización. El ayuntamiento destina unos 40 mil dólares para las fiestas.
De acuerdo con el vicealcalde Patricio Guayllasaca, la agenda festiva genera alternativas para que se reactive la economía de los habitantes, especialmente para que expongan sus artesanías, productos y platos típicos a los turistas.
Las actividades comerciales en Sígsig se reactivaron desde enero del presente año. Guayllasaca recordó que en Carnaval se contó con una importante presencia de turistas por los eventos masivos con el aforo del 100 %. Lo mismo se espera para las fiestas de emancipación política con los eventos programados. (BPR)-(I)
Agenda de actividades
Chordeleg
En Chordeleg, hoy, desde las 11:30, en el barrio Remate-Gausal, se entregará una cubierta metálica; y mañana, desde las 12:00, en el sector Llaver, se inaugurará el parque recreativo.
El sábado, a las 10:00, por las principales calles, se llevará cabo el desfile cívico-cultural-militar; a las 14:00, en el polideportivo, será la sesión solemne. El domingo, a las 14:00, en la plaza “José María Vargas”, será la elección de la Cholita Chordelense.
Oña
En Oña comenzarán las fiestas el domingo, a las 09:00, por las calles céntricas, con el pregón de aniversario. El 30 de abril, a las 20:00, en el coliseo municipal, será la elección de la reina del cantón.
El 8 de mayo, a las 09:00, en las calles céntricas, se efectuará la Feria productiva y turística. El 10 de mayo, a las 09:30, por las principales calles, será el desfile estudiantil-cívico-militar; y a las 13:00, en el salón de la ciudad, la sesión solemne.
Sígsig
En Sígsig empezaron el último sábado los festejos por los 158 años de cantonización, con la colocación de la ofrenda floral en el parque central. El viernes, a las 08:00, en la iglesia matriz, se celebrará una eucaristía; y a las 19:30, en las multicanchas, será el Festival de la canción nacional.
El domingo, a las 09:00, por las principales calles, será el desfile cívico-militar; a las 10:00, en las multicanchas, la Feria gastronómica y artesanal; y a las 11:00, en el coliseo municipal, la sesión solemne.